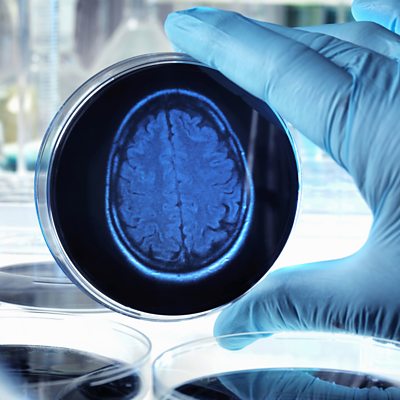

Episode details
Available for over a year
Just months after the ‘momentous’ announcement of the first drug shown to slow the effects of Alzheimer’s disease, the results of a global trial into another have been published. The antibody medicine donanemab helped people in the early stages of Alzheimer’s by slowing the pace of the brain’s decline by about a third. Dr Graham Easton joins Claudia Hammond to look at what another ‘breakthrough’ means in practice. They also look at new evidence from the USA that giving hearing aids to older people at risk from dementia could be another way to slow cognitive decline in some people. While caring for women in childbirth, midwives are expected to be compassionate. Claudia hears from Dr Halima Musa Abdul, Senior Lecturer in Nursing Science at Ahmadu Bello University in Nigeria, and to Dr Kaveri Mayra, who trained in India and is now a researcher at the University of British Columbia. They say that particularly in lower and middle income countries, midwives aren’t being shown enough compassion at work themselves. And we hear from Germany where a portable brain scanner could provide a solution for people in hard-to-reach health clinics. Image Credit: Andrew Brookes Presenter: Claudia Hammond Producer: Clare Salisbury & Dan Welsh
Programme Website